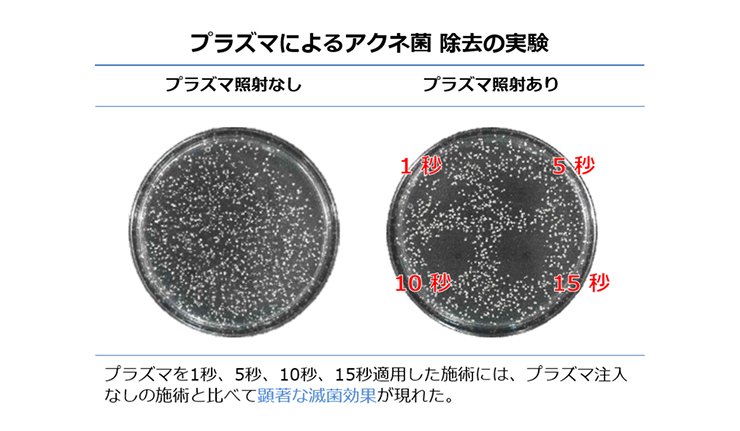

ピーリング・導入治療
プラズマシャワー
低温プラズマで殺菌+美容成分を深層導入
肌あれ・ニキビ・くすみ・毛穴
Treatment menu
プラズマシャワーとは
電気エネルギーを持つイオン化された気体「プラズマ」の特性を活かした美肌治療がプラズマシャワーです。皮膚表面では、高い滅菌力で肌トラブルを引き起こす細菌を死滅させてニキビや肌荒れを改善、真皮では線維芽細胞を刺激してコラ―ゲンの再生を促し、肌にハリをもたらします。さらに注目すべきは、施術後に導入する薬剤の吸収率を高める「ドラッグデリバリー」効果です。一時的に細胞の結合を切断することで、お悩みに応じた薬剤を効率よくお肌の奥まで浸透させることができます。当院では最後の仕上げに、成長因子やヒアルロン酸などの美容成分をたっぷり含んだパックを行い、素肌の美しさをさらに高めます。施術時間は短く、痛みやダウンタイムもほとんどありません。翌朝から美肌効果を実感できるため、お肌の衰えを感じるときはもちろん、大切な予定の前のスペシャルケアとしてもおすすめです。
Doctor's Voice
慶田院長 からの おすすめポイント

「肌再生」のスイッチを入れること、老化や外的刺激による「炎症」を鎮めること、この2つはアンチエイジング治療に欠かせません。そのためには肌から直接薬剤を導入するのが一番です。でも、高機能な成分は、高分子で、普通に塗っても吸収されません。皮膚に確実に届けるには、レーザーや針を使うと確実で、それらの刺激によるコラーゲン線維増生作用もうれしいのですが、毎週受けるのは難しいですよね。 プラズマシャワーは、高い殺菌効果で肌フローラを整え、コラーゲンを再生するスイッチを入れる新しいジャンルのマシンです。毎週でも受けて頂ける、ノンストレス施術でありながら、薬剤を確実に導入できる点が優れています。ニキビやアトピー性皮膚炎でお悩みの方にもおすすめです。痛みやダウンタイムが無くて、簡単に綺麗な肌になりたい!そんなワガママを叶えるプラズマシャワーをぜひご体験ください。翌朝の美肌効果にきっとご満足いただけると思います。
こんな方におすすめ
- ニキビ、肌荒れを改善したい方
- くすみが気になる、肌をトーンアップさせたい方
- 肌にハリやツヤを持たせたい方
- ダウンタイムなく美肌ケアをしたい方
プラズマシャワー
の特徴
- プラズマの肌への効果
強力な滅菌効果
プラズマは以前から、医療の分野では器機の滅菌などに使われてきました。 この技術をお肌に応用して、肌トラブルを引き起こす細菌を死滅させ、ニキビや肌荒れを改善します。また、アトピー性皮膚炎の皮疹部に増え、炎症を悪化させる黄色ブドウ球菌の滅菌にも効果的です。図は、プラズマのアクネ菌除去実験の結果です。照射した箇所では、明らかにアクネ菌が死滅しているのがわかります。プラズマ照射後の滅菌された清潔な肌に、薬剤(美肌成分)を浸透させることができるので肌トラブルになりにくく、安全性の高い治療法です。
美白効果

プラズマイオンが皮膚の古い角質や異物を弾き飛ばし、くすみを改善します。施術後、美白効果の高い薬剤を導入すると、さらに肌色がワントーン上がり、透明感のある明るい肌を手に入れることができます。
皮膚再生効果
プラズマを照射すると細胞組織の帯電バランス(イオンバランス)が整い皮膚が引き締まります。また、線維芽細胞を刺激しコラーゲン・エラスチンの産生を高め、皮膚老化を防止し、肌のハリを改善します。
TDDS(経皮ドラッグデリバリーシステム)による高い浸透効果

プラズマ照射後は、皮膚細胞を結合している細胞接着分子(CAMs)が一時的に切り離されるため、お悩みに応じた薬剤を皮膚表面に塗布するだけで確実に肌の奥に浸透させることが可能です。
- お悩みに合わせて選べる3つのプラズマコース
ニキビプラズマコース:ニキビ・アトピー性皮膚炎・炎症後色素沈着の改善・美白
薬剤:トラネキサム酸
トラネキサム酸は、抗プラスミン作用を持つ薬用アミノ酸です。メラニンを作り出す前の段階でメラノサイトの活性を阻害し、肝斑やシミ、くすみを防ぎます。また、抗アレルギー、抗炎症作用も併せ持つので、アトピー性皮膚炎、肌荒れ、ニキビによる炎症、日焼けによる炎症も鎮静します。
白雪プラズマコース:シミ・肝斑・くすみ・加齢による肌の衰え・乾燥の改善
薬剤:トラネキサム酸+白雪注射

「肌再生(PDRN)」「美白(グルタチオン)」「保湿(非架橋ヒアルロン酸)」の3つの効果を兼ね備えた薬剤です。加齢・紫外線・乾燥などのダメージを受けた肌を修復・再生し、潤いと透明感の高い肌に導きます。
肌再生プラズマコース:老化によるシミ・シワ・毛穴の根本改善・ニキビ・アトピー性皮膚炎の改善
薬剤:トラネキサム酸+ファクター9(乳歯幹細胞培養上清液)

ヒト乳歯由来の歯髄幹細胞を培養する過程で得られる上清(培養液の上澄み)を精製したものです。幹細胞が分泌するさまざまな有用成分が含まれており、サイトカイン、成長因子、エクソソームなどが豊富に含有されています。これらの成分は、細胞同士の情報伝達を担う「生体シグナル」として働き、肌のコンディションを整えながら、本来備わっている修復機能をサポートします。炎症を抑え、肌のハリや弾力に関わる線維芽細胞を活性化し、コラーゲンの産生を促進することで、加齢や紫外線などの影響で低下した肌の再生力にアプローチします。その結果、小ジワやたるみ、くすみなどのエイジングサインを総合的にケアし、健やかでなめらかな肌へと導きます。また、炎症バランスを整える作用により、ニキビやアトピー性皮膚炎などの肌トラブルに対する補助的なケアとしても期待されています。
- 仕上げの『濃密パック』で効果を最大限に引き出す
当院では、仕上げに、細胞の修復や再生を促す成長因子「EGF」や「ヒアルロン酸」などの保湿成分をたっぷり含んだ密着性の高いパックを行い、ハリのあるみずみずしい肌へ導きます。
植物由来の新素材「バイオセルロース」を使用したゲル状のパック

①細胞の修復や再生を強力に促す成長因子「EGF」
②抗炎症作用のある「グリチルリチン酸2K」
③柔らかく滑らかな肌へと導く「アセチルヘキサペプチド」
④保湿作用に優れている「サクシニルアテロコラーゲン」
⑤優れた保水性と浸透力のある「ヒアルロン酸Na」無香料、無着色でパラベン、フェノキシエタノール、アルコール、界面活性剤など、肌に刺激を与える成分は含まれておりません。
- 他の施術との比較
イオン導入との違い

イオン導入は、イオン化できる分子量の小さな物質(ビタミンC誘導体、トラネキサム酸、アミノ酸など)を電気の反発力を利用して肌の内部に浸透させます。そのため、イオン化できない、もしくは分子量の大きい物質は導入できないという欠点がありました。
プラズマシャワーは、薬剤の種類を選ばず浸透させることができます。薬剤の浸透力はより強力です。さらに照射単独の効果として、強力な滅菌作用で、ニキビをはじめとするさまざまな皮膚トラブルを引き起こす細菌を死滅させ、真皮では線維芽細胞を刺激して、コラーゲン・エラスチンの産生を高め、皮膚のハリやツヤを高めます。
適応部位と効果
プラズマシャワーで改善できるお悩みとその効果をご紹介します。
顔の適応部位
身体の適応部位
症例写真
before
after
医師による症例
の解説
施術前は、全体的にカサカサして荒れた状態(痒みもあり)で、赤みによる色ムラが目立ちました。『プラズマシャワー』の高い滅菌力と「サイトプロMD」の抗炎症作用で、肌フローラが整って炎症反応が鎮静し、赤みが改善され色ムラが目立たなくなりました。キメが整い透明感も出ています。
施術内容
| 年代 | 20代女性 |
|---|---|
| お悩み | アトピー性皮膚炎、花粉皮膚炎による赤み改善 |
| 施術名 | プラズマシャワー 肌再生コース(サイトプロMD) |
| 施術回数 | 2回 |
| 費用 | トライアル¥28,000 通常¥38,000 |
| リスク・副作用 | 頻度は低いですが紅斑や導入薬剤によるアレルギー |
推奨回数と施術間隔
1~4週間に1回の間隔で3~5回
患者様のお肌の状態によって適切な頻度は異なるため、カウンセリング時に医師が最適なプランをご提案いたします。
効果の現れ方
個人差はありますが、施術直後から潤い・肌の明るさ・ハリ感を実感される方が多くいらっしゃいます。炎症を鎮める作用もあり、ニキビや肌荒れによる赤みも落ち着きやすくなります。さらに、繰り返し施術を受けることで、ニキビをはじめとする肌トラブルが起こりにくい健やかな肌へと導きます。
メンテナンス
1ヶ月に1回のペースで継続していただくと、肌質改善や美肌維持に効果的です。また、お肌の衰えを感じるときや、大切なご予定の前のスペシャルケアとしてもおすすめです。
概要・リスク・
ダウンタイム
| 所要時間 | 約30分程度 |
|---|---|
| 麻酔 | 不要 |
| 痛み | ほとんどなく、無感覚からわずかに温かさを感じる程度です。 |
| ダウンタイム | ほとんどありません。稀にほてりや赤みが生じることがありますが、数時間で落ち着きます。 |
| 副作用・リスク | 赤み・熱感・導入薬剤によるアレルギー |
| 日常生活 | 施術後30分間は導入効果が持続するため、指定の薬剤以外は何も塗布しないでください。洗顔、入浴、メイクは、1時間後から可能です。 |
施術をお受けいただけない方
- 強い日焼けをされた直後の方
- 施術部位に傷や重篤な皮膚疾患や感染症がある方
- 重度の糖尿病、悪性腫瘍、心疾患、出血性疾患、ケロイド体質の方
- 使用する機器や導入薬剤に対して、過去にアレルギーやトラブルを起こしたことがある方
※安全のため、他院での美容医療の治療歴や内服中のお薬についても、必ず担当医師にお伝えください。
使用する医療機器・医薬品について
医薬品医療機器等法上の承認
未承認
入手経路等の明示
韓国SEOULIN MEDICARE社製造
当院医師の判断のもと、国内正規代理店を通じて、正式な手続きにより個人輸入しています。
※個人輸入における注意すべき医薬品等に関する情報は、下記をご参照ください。
<a href="https://www.yakubutsu.mhlw.go.jp/individualimport/purchase/index.html" target="_blank" rel="noopener noreferrer">https://www.yakubutsu.mhlw.go.jp/individualimport/purchase/index.html</a>
同一成分、同一性能の国内承認医薬品等の有無の明示
無
諸外国における安全性等に係る情報の明示
以下の認証を取得しております。
・韓国-MFDS(旧KFDA)
・米国-FDA
・欧州-CEマーク
※未承認医療機器等は、国の医薬品副作用被害救済制度の救済の対象外となります。予めご了承下さい。
料金
ベーシックコース【トラネキサム酸導入】
ニキビ・アトピー性皮膚炎・炎症後色素沈着の改善・美白
| 部位 | 初回トライアル | 1回 | 3回 (5%OFF) |
5回 (10%OFF) |
|---|---|---|---|---|
| 顔全体・首前面・手の甲 各1部位 | ¥16,500 | ¥22,000 |
¥62,700 1回あたり¥20,900 |
¥99,000 1回あたり¥19,800 |
| 顔全体~首前面 | ¥22,000 | ¥33,000 |
¥94,050 1回あたり¥31,350 |
¥148,500 1回あたり¥29,700 |
| 部位 | 顔全体・首前面・手の甲 各1部位 |
|---|
| 初回トライアル | 1回 | 3回 (5%OFF) |
5回 (10%OFF) |
|---|---|---|---|
| ¥16,500 | ¥22,000 |
¥62,700 1回あたり¥20,900 |
¥99,000 1回あたり¥19,800 |
| 部位 | 顔全体~首前面 |
|---|
| 初回トライアル | 1回 | 3回 (5%OFF) |
5回 (10%OFF) |
|---|---|---|---|
| ¥22,000 | ¥33,000 |
¥94,050 1回あたり¥31,350 |
¥148,500 1回あたり¥29,700 |
美容成分をたっぷり含んだ濃密パック込み(首・手の甲は除く)
白雪コース【ベーシックコース+白雪導入】
シミ・肝斑・くすみ・加齢による肌の衰えの改善
| 種類 | 追加料金 |
|---|---|
| 白雪注射 | 1回あたり¥4,400 |
肌再生コース【ベーシックコース+ファクター9(乳歯幹細胞培養上清液)導入】
ニキビ・アトピー性皮膚炎の改善、老化によるシミ・シワ・毛穴の根本改善
| 種類 | 追加料金 |
|---|---|
| ファクター9(乳歯幹細胞培養上清液) | 1回あたり¥8,800 |
白雪コース・肌再生コースは、都度導入追加料金がかかります。